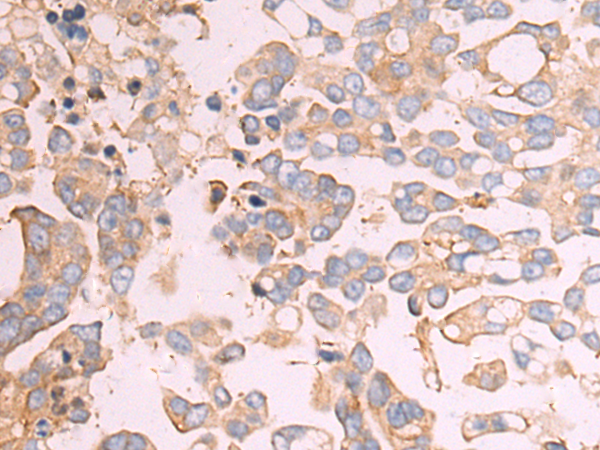
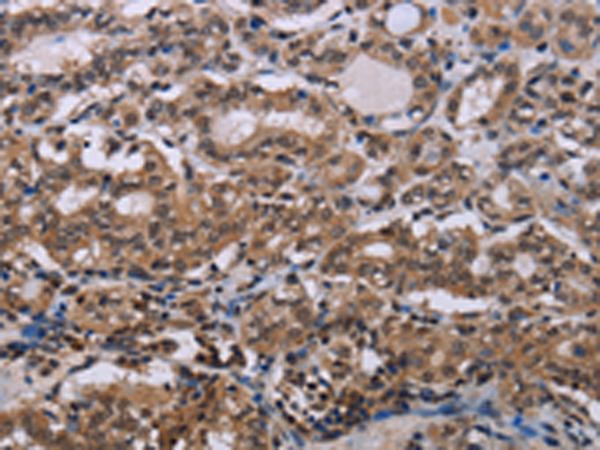

-
分类: 科研抗体货号: P01323别名: ELC2; HPC2; COXPD17应用: WB,IHC反应种属: Human, Mouse, Rat
-
分类: 科研抗体货号: P01266别名: DACH应用: WB,IHC反应种属: Human, Mouse
-
分类: 科研抗体货号: P01299别名: DP1; Dp-1; DRTF1应用: WB反应种属: Human, Mouse
-
分类: 科研抗体货号: P01321别名: CAB; EIF3A; eIF-6; p27BBP; ITGB4BP; b(2)gcn; p27(BBP)应用: WB,IHC反应种属: Human, Mouse, Rat
-
分类: 科研抗体货号: P01368别名: 16G2; Gugu; IRL685应用: WB反应种属: Human
-
分类: 科研抗体货号: P01295别名: DjB4; HLJ1; DNAJW应用: WB,IHC反应种属: Human, Mouse
-
分类: 科研抗体货号: P01318别名: MRT67; EIF3S5; eIF3-p47应用: WB,IHC反应种属: Human, Mouse
-
分类: 科研抗体货号: P01363别名:应用: IHC反应种属: Human
-
分类: 科研抗体货号: P01293别名: BP1; DLX7; DLX8; DLX9应用: IHC反应种属: Human
-
分类: 科研抗体货号: P01308别名:应用: WB,IHC反应种属: Human, Mouse

鄂公网安备42018502007531号
鄂公网安备42018502007531号

